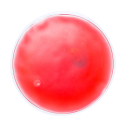
Wärmekissen Relief

Haben Sie Fragen zu unseren Werbeartikeln und wie man diese mit Logo bedrucken kann? Dann finden Sie hier häufig gestellte Fragen und Antworten.
Was sind Werbeartikel?
Werbeartikel sind speziell markierte Produkte mit einer Botschaft, die von Unternehmen als Teil ihrer Marketing-Strategie eingesetzt werden. Sie tragen in der Regel das Firmenlogo, den Markennamen oder einen Werbeslogan und werden kostenlos an Kunden oder potenzielle Kunden verteilt. Der Zweck von Werbemitteln ist es, die Sichtbarkeit der Marke zu erhöhen und eine dauerhafte Erinnerung an das Unternehmen zu schaffen.
Welche Vorteile bieten Werbemittel mit Logo für Unternehmen?
Werbemittel mit Logo stärken die Markenbekanntheit, schaffen Wiedererkennungswert und fördern die Kundenbindung. Sie erhöhen die Reichweite durch alltägliche Nutzung und wirken positiv auf die Wahrnehmung einer Firma. Zudem sind günstige Streuartikel kosteneffizient, vielseitig einsetzbar und ermöglichen gezieltes Marketing. Langfristig steigern sie Vertrauen und Loyalität bei Kunden und Geschäftspartnern.
Sind Werbemittel noch zeitgemäß?
Ja, bedruckte Werbeartikel sind noch zeitgemäß, denn Werbemittel sind nach wie vor ein zentraler Faktor in der Werbestrategie von Unternehmen. Sie vertiefen die physische Verbindung zu Kunden und Mitarbeitern, schaffen langanhaltende Erinnerungen, sind vielseitig und verleihen Ihrem Business eine individuelle Note.
Wer braucht Werbeartikel?
Firmen jeder Art und Branche profitieren von bedruckten Werbegeschenken. Werbeartikel mit Logo sind ein effektives Mittel, um die Markenbekanntheit zu steigern und das öffentliche Image zu festigen. Daher sollte jedes Unternehmen Werbemittel in seine Marketing-Kampagnen integrieren.
Was kosten Werbeartikel mit Firmenlogo durchschnittlich?
Die Kosten für Werbeartikel mit Firmenlogo variieren je nach Artikel, Material, Druckverfahren und Bestellmenge. Günstige Werbeartikel wie Kugelschreiber starten bei 0,20-1,00 € pro Stück, während hochwertige Werbeartikel wie Powerbanks oder Taschen 5-20 € kosten können. Mengenrabatte senken die Stückkosten bei größeren Bestellungen natürlich erheblich.
Was sind die besten Werbeartikel?
Die bekanntesten, beliebtesten oder besten Werbeartikel sind Regenschirme, Süßigkeiten, Taschen, Tassen, Thermobecher, Sonnenbrillen, Schlüsselbänder, Flaschen, Stifte und Feuerzeuge. Darüber hinaus gewinnen nachhaltige Werbeartikel immer mehr an Beliebtheit und hinterlassen einen positiven Eindruck. Entdecken Sie in unserem Werbeartikel-Shop eine Vielzahl von hochwertigen Werbemitteln, die Ihren Bedürfnissen entsprechen.
Warum sollte ich Werbeartikel einsetzen?
Werbeartikel mit Firmenlogo sind effektive Marketinginstrumente, um die Botschaft einer Firma zielgerichtet an die Zielgruppe zu kommunizieren. Durch den Einsatz von Werbeträgern können Kunden gewonnen, Umsätze gesteigert, die Bekanntheit erhöht und neue Produkte beworben werden. Werbeartikel bieten zudem eine gute Möglichkeit, um eine langfristige Bindung zu Kunden aufzubauen und ihre Markentreue zu stärken.
Wie wählt man passende Werbeartikel aus?
Wählen Sie Werbeartikel, die zu Ihrer Zielgruppe passen und einen praktischen Nutzen haben. Achten Sie außerdem auf Qualität – minderwertige Artikel können Ihrem Unternehmensimage schaden. Berücksichtigen Sie zudem Budget, die Werbefläche für das Logo und ob der Artikel zum Anlass passt. Nachhaltige und langlebige Geschenke bleiben dabei stets länger in Erinnerung.
Welche Funktion erfüllen Werbemittel im Marketing-Mix?
Werbemittel sind Teil der Kommunikationspolitik im Marketing-Mix. Sie steigern die Markenbekanntheit, stärken die Kundenbindung und schaffen wiederkehrende Kontaktpunkte zur Zielgruppe. Als greifbare Markenbotschafter transportieren sie Werte und sorgen für positive Assoziationen. Werbeartikel mit Logo unterstützen zudem andere Marketingmaßnahmen und erhöhen die Sichtbarkeit Ihrer Marke im Alltag der Kunden.
Was denken Kunden über personalisierte Werbeartikel?
Kunden schätzen personalisierte Werbeartikel, da sie Wertschätzung vermitteln und nützlich sind. Sie hinterlassen einen positiven Eindruck und stärken die Bindung zur Marke. Praktische oder hochwertige Werbeartikel werden übrigens besonders geschätzt, da sie im Alltag Verwendung finden. Zudem steigern Werbegeschenke mit Logo die Wahrnehmung des Unternehmens als aufmerksam und kundenorientiert.
Was sind typische Werbemittel?
Typische, oder auch klassische Werbemittel sind: Bedruckte Give-aways und Streuartikel, Werbeartikel, Werbegeschenke, Werbeanzeigen (digital und Print), Werbeplakate und Werbebanner, Werbespots (TV und Rundfunk), Werbeflyer und Prospekte
Kann ich Werbeartikel & Werbemittel mit Druck auch in kleinen Mengen bestellen?
Ja, bei Brandible können Sie Werbegeschenke mit Druck je nach Produkt auch schon in Kleinstmengen bedrucken lassen. Einige unserer Werbeartikel mit Logo sind sogar bereits ab 1 Stück bedruckbar.
Welche Werbemittel sind am effektivsten zur Kundenbindung?
Effektive Werbemittel zur Kundenbindung zeichnen sich durch ihre alltägliche Nützlichkeit und Sichtbarkeit aus. Kugelschreiber, Notizblöcke und USB-Sticks gehören zu den kostengünstigen und praktischen Optionen, während Tragetaschen, T-Shirts und Trinkflaschen aufgrund ihrer breiten Anwendung und langen Lebensdauer besonders beliebt sind. Die Wirksamkeit eines Werbeartikels hängt stark von seiner Relevanz für die Zielgruppe und der Einbindung in eine strategische Marketingplanung ab.
Welche Werbegeschenke bleiben im Kopf?
Werbegeschenke, die im Kopf bleiben sollen, müssen nützlich, hochwertig und kreativ sein. Beispiele: personalisierte Trinkflaschen, nachhaltige Produkte wie Bambus-Stifte, technische Gadgets (Powerbanks, USB-Sticks), oder etwas Einzigartiges wie Mini-Pflanzen. Entscheidend ist, dass sie emotional ansprechen, im Alltag verwendet werden und Ihre Marke clever präsentieren. Funktionalität und Individualität machen bei Werbegeschenken den Unterschied!
Wie verteilt man Werbeartikel mit Logo am besten?
Die Verteilung von bedruckten Werbeartikeln kann auf Veranstaltungen, Messen, durch Direktmailings oder als Teil von Kundenbestellungen erfolgen. Wichtig ist, dass der Werbeartikel mit Logo einen Mehrwert für den Empfänger hat und in einem passenden Kontext übergeben wird.
Ist der Einsatz von Werbeartikeln problematisch?
Der Einsatz von Werbeartikeln kann lediglich problematisch sein, wenn die Produkte von geringer Qualität, unpraktisch oder umweltschädlich sind. Überflüssige Werbemittel verschwenden zudem Ressourcen und können negative Reaktionen hervorrufen. Nachhaltigkeit, Zielgruppenrelevanz und Qualität sind entscheidend, um diese Probleme zu vermeiden und den positiven Effekt von Werbeartikeln zu maximieren.
Gibt es Trends bei Werbeartikeln 2026?
2026 dominieren nachhaltige und umweltfreundliche Werbeartikel aus recycelten oder natürlichen Materialien. Tech-Produkte wie kabellose Ladegeräte und Smart-Gadgets bleiben ebenfalls beliebt. Gesundheits- und Wellness-Artikel, Hybrid-Work-Zubehör für Homeoffice und hochwertige, personalisierte Produkte liegen außerdem im Trend. Regionalität und kurze Lieferketten gewinnen 2026 bei Werbeartikeln noch mehr an Bedeutung.